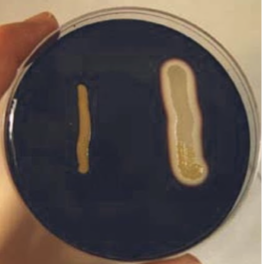
<ol><li><p>what test is this?/ what does it test for?</p></li><li><p>whats making this blue color?/ what media is this</p></li><li><p>which is a positive and negative result and explain what’s happening to yield such results</p></li></ol><p></p>

1/202
(ex 14-22)
Name | Mastery | Learn | Test | Matching | Spaced | Call with Kai |
|---|
No analytics yet
Send a link to your students to track their progress
the sum of all chemical reactions (bioenergetics, biosynthesis, and biodegredation
cellular metabolism
the biochemical transformations that occur both outside and inside the cell are governed by biological catalysts
enzymes
extracellular enzymes
exoenzymes
exoenzymes aka
extracellular enzymes
why do we need exoenzymes? what are they used for?
exoenzymes help to break down high molecular weight substances that aren’t able to pass through cell membranes (polysaccharides, lipids, and proteins) into low molecular weight materials(aka nutrients) so they can be transported into the cell
what do exoenzymes do and how do they do it?
exoenzymes help break down high molecular weight substances like polysaccharides, proteins, and lipids that can’t pass through the cell membrane into their building blocks by introducing a water molecule to break them up so they can be transported into the cell
exoenxymes are mainly what? and why does this make sense
mainly hydrolytic enzymes *makes sense because they add a water to the high molecular weight molecule to break it down so it can get into the cell (macro molecule + water —> nutrients)
enzymes that can act on substances outside of the cell; mainly hydrolytic enzymes that reduce high molecular weight materials into their building blocks by introducing water into the molecule, liberating smaller molecules which may then be transported into the cell
exoenzymes
polymer —→ monomer via ?
extracellular enzymes
give examples of molecules extracellular enzymes break down
proteins, carbohydrates (via amylose), fiber, fats (lipids), and DNA
intracellular enzymes
endoenzymes
endoenzymes aka
intracellular anzymes
monomers in the ECM—> into cell via?
extracellular enzymes (endoenzymes)
what do endoenzymes do?/ whats the result?
mainly responsible for the synthesis of new protoplasmic requirements (*see section 2*) and production of cellular energy from assimilated materials. breaks substrates into essential materials which are vital for cellular survival and function (it’s the basis for cellular metabolism). As a result of these metabolic processes, metabolic products are formed and excreted by the cell into the environment. Assay of these end products not only acids in identification of specific enzyme systems also serve to identify, separate, and classify microorganisms.
how can you detect the presence of endoenzymes?
the ability of cells to act on nutritional substrates permeating cell membranes indicates the presence of many endoenzymes capable of transforming chemically specific substrates into essential materials
What are the bioichemical activities of microorganisms associated with extracellular (exoenzymes) enzymes?/what tests are done to investigate the exoenzymatic activities of different microorganisms?
starch hydrolysis (polysaccharide)
lipid hydrolysis (tributyrin)
gelatin hydrolysis (protein)
What are the bioichemical activities of microorganisms associated with intracellular (endoenzymes) enzymes?what tests are done to investigate the endoenzymatic activities of different microorganisms?
carbohydrate fermentation
litmus milk reactions
hydrogen sulfide production
nitrate reduction
catalase reactions
urease test
oxidase test
IMViC test (indole)- methyl red, voges-proskauer, citrate utilization
triple sugar-iron test
*8 & 9 are used for the separation of enteric microorganisms!
start of exercise 14
Starch hydrolysis:
define starch
what is the main enzyme associated with the degradation of starch?
give the full breakdown of starch
does this test endoenzymatic activity or exoenzymatic activity?
what is the purpose of this test?
what media used?
do you need to add a reagent? if so what?/ give its purpose/ and for how long?
what does a positive result look like?/ what does this mean?
what does a negative result look like?/ what does this mean?
a high molecular-weight branching polymer composed of glucose molecules linked together via glycosidic bonds
amylase
starch (via amylase—> dextrins—> malatose (via malatase—> glucose (—> transported into the cell)
exoenzymatic activity
to test for the hydrolytic activity of amylase/ to see if theres a presence or absence of starch in the media
starch agar
yes! (gram’s IODINE must be used - flood plate and let it sit for 30 seconds, and then pour off the excess). Iodine binds to starch, producing a blue/black color!)
positive result: halo around streak line of organism and then blue/black medium surrounding halo (presence of starch degradating enzymes like amylase) — glucose produced
negative result: no halo (just surrounded by blue/black medium)= absence of starch- hydrolyzing enzymes (starch not broken down so no glucose)
what test is this?/ what does it test for?
whats making this blue color?/ what media is this
which is a positive and negative result and explain what’s happening to yield such results
starch hydrolysis test; tests for the presence or absence of starch in a medium (exoenzymatic activity)
gram’s iodine is added after the plates have been incubated for 30 seconds and binds to starch/ starch agar
right= positive result (indicated by halo; this halo represents the hydrolysis of starch, micoorganism produces starch hydrolyzing enxymes))
left= negative (indicated by lack of halo; no halo means that there aren’t starch splitting enzymes, microorganism can’t break down starch)
Lipid hydrolysis:
define lipid and give its aka
what is the main enzyme associated with the degradation of lipids?
give the full breakdown of lipids
does this test endoenzymatic activity or exoenzymatic activity?
what is the purpose of this test?
what media used?+ why
do you need to add a reagent? if so what?/ give its purpose/ and for how long?
what does a positive result look like?/ what does this mean?
what does a negative result look like?/ what does this mean?
lipids aka triglycerides are high-molecular weight compounds possessing of large amounts of energy (can serve as bacterial carbon source that are too large to enter the cell)
lipases (cleave ester bonds)
lipids (triglycerides) (=O) + H2O (via lipase)—> glycerol + fatty acids (COOH) (can be used during aerobic respiration to produce ATP)
exoenzymatic actvity
tests to see if a microorganism possesses lipases (a type of exoenzyme) to breakdown lipids (triglycerides)
tributyrin agar (tributyrin agar is nutrient agar with tributyrin substituted as a lipid substrate that forms an emulsion when dispersed in agar! it looks opaque normally!)
no!
positive result= zone of lipolysis (clear/transparent zone/area around bacterial growth line) indicates hydrolysis of tributyrin—> this loss of opacity is the result of the hydrolytic reaction of lipids into soluble glycerol (a type of alcohol) and fatty acids)
negative result= no clearing; remains opaque around the bacterial growth, no exoenzyme (lipase in particular)

what test is this?/ what does it test for?
what media is this?
+ 4. which is a positive and negative result and explain what’s happening to yield such results
lipid (tributyrin) hydrolysis
tributyrin agar
right positive result= zone of lipolysis (clear/ transparent zone/ area around bacterial growth line) indicates hydrolysis of tributyrin—> this loss of opacity is the result of the hydrolytic reaction of lipids into soluble glycerol (a type of alcohol) and fatty acids)
left negative result= no clearing; remains opaque around the bacterial growth, no exoenzyme (lipase in particular)
Gelatin hydrolysis:
define gelatin
what is the main enzyme associated with the degradation of gelatin?
give the full breakdown of gelatin
give temperature specifics
does this test endoenzymatic activity or exoenzymatic activity?
what is the purpose of this test?
what media used?+ why
do you need to add a reagent? if so what?/ give its purpose/ and for how long?
what do you do to interpret the results if you don’t have to add a reagent
what does a positive result look like?/ what does this mean?
what does a negative result look like?/ what does this mean?
gelatin is a protein produced by the hydrolysis of collagen - makes up connective tissues in vertebrate animals (it’s a polymer of the protein, collagen)
gelatinase (aka collagenase)
gelatin (via gelatinase aka collagenase—> amino acids
below 25C= solid; above 25 C= liquid! *gelatin that has remained hydrolyzed can’t be re-solidified even at 4C
exoenzymatic activity
to test for the degredation of gelatin into amino acids (gelatin hydrolysis)
gelatin deep (inoculated via stab inoculation)
you need to refrigerate them at 4C after incubation, but you don’t have to do this!
tilt dat hoe!
positive result = liquid (tilt it and see if there’s a bump)= low levels of gelatin; gelatin hydrolysis
negative result= solid= high concentration of gelatin = stiff medium (doesn’t move when you tilt it)

what test is this?/ what does it test for?
what media is this?
+ 4. which is a positive and negative result and explain what’s happening to yield such results
gelatin hydrolysis (tests for the degradation of gelatin/ the presence of gelatinase/ collagenase in microorganisms
gelatin deep
positive result = liquid (tilt it and see if there’s a bump)= low levels of gelatin; gelatin hydrolysis
negative result= solid= high concentration of gelatin = stiff medium (doesn’t move when you tilt it)
start of exercise 15
glycolysis aka
Embden-Meyerhof pathway
what does glycolysis do
converts 1 mol of glucose into 2 mol of pyruvate
cellular respiration is classified into 2 groups: aerobic and anaerobic, explain the difference between the 2
aerobic: molecular oxygen serves as the final electron acceptor (more ATP generated)
anaerobic: inorganic ions other than oxygen are final electron acceptor
fermentation
define
explain
an anaerobic breakdown of substrates like carbohydrates and alcohols with the production of organic acids and sometimes gases such as H2 or CO2
doesn’t require O2; organic substrate serves as final electron acceptor; some organisms can use one or the other, some use both, depending on carbohydrate source and O2 availability
fermentation vs. cellular respiration in terms of ATP production
fermentation
phenol red
what test is it associated with?
what properties does it have?
for MacConkey Agar, explain what the color change means
for carbohydrate fermentation, explain what the color change means
carbohydrate fermentation (endozymatic activities) + MacConkey Agar (selective for gram negative Enterobacteriacae)
neutral pH= 7 and is red
MacConkey Agar: trick question MacConkey uses NEUTRAL RED!!!
carbohydrate fermentation: below pH of 6.8= yellow (carbohydrate fermentation), above 8.2-
Carbohydrate fermentation test
does this test endoenzymatic activity or exoenzymatic activity?
what is the purpose of this test?
what media used?+ anything else useful? why
do you need to add a reagent? if so what?/ give its purpose/ and for how long?
what do you look at to interpret the results?
what does a positive result look like?/ what does this mean?
what does a negative result look like?/ what does this mean?
endoenzymatic activity
fermentation of glucose or lactose
trypticase soy nutrient broth + carbohydrate + pH indicator (Phenol red)= indicator of acid production, durham tube= indicator of the presence of air bubbles/gas)
no
for gas production look at the durham tube, for carbohydrate fermentation look at the color of the medium, the color will determine the results; carbohydrate fermentation results in a more acidic pH!!; more acidic pH will cause it to turn from red to yellow
positive results: 1) Acid production red—> yellow! (pH is below 6.8, sugar is metabolized) + no gas bubble in durham tube / yellow + gas bubble in durham tube) 2) Acid + gas production (yellow +gas bubble; fermentation indicated by color change to yellow and gas is trapped in durham tube (bubble shown)
negative results 2 ways: 1. no color change= red- sugar not used by the organism, 2. color change from red to dark pink-ish red (pH above 8.2)= not using sugar as energy source, can be using peptones (peptonization) from nutrient broth instead) indicated (ammonium) alkaline or basic metabolic products + NO BUBBLES
Start of exercise 16
what does IMViC stand for?
Indole Methyl Red Voges - Proskauer Citrate Utilization test
IMViC Tests:
define
what are they used for generally?
why are they used
Indole Methyl Red Voges - Proskauer Citrate Utilization test
differentiate members of Enterobacteriaceae (short, gram (-), non-spore forming bacteria (this includes members of the genera Salmonella, Shigella, occasional pathogens of Klebsiella, and Proteus, normal intestinal microbiota aka flora of the genera Eschrichia and Enterobacter (saprophytic inhabitants of the intestinal tract)
too hard to differentiate based on one test
what are tryptanophase positive bacteria?
bacteria that will de-aminate tryptophan and produce indole!
Indole Test
what is it used for? (general)
what does it test for?
explain the breakdown of the thing this test tests for
what type of media is used?
do you need to add a reagent/ if so which one and how before interpreting results?
what do you look at to interpret the results?
positive looks like?/what does this mean?
negative result looks like?/ what does this mean?
to help differentiate members of the genus Enterobacteriaceae
tests to see if the bacteria present in a sample can hydrolyze the amino acid tryptophan
tryptophan +H2O (via tryptophanase—> indole + pyruvic acid + ammonium
SIM agar medium (stab inoculation)
yes! Kovac’s reagent (add 10 drops and swirl gently) (kovac’s reagent reacts with indole to produce a color change)
look at the ring at the top of the SIM agar deep tube; before adding kovac’s reagent SIM agar deep tubs looks light yellow
positive result: cherry red layer at the top (kovac’s reagent reacts with indole, producing a red/ pink color), indicative that that bacteria can break down tryptophan into indole
negative result= dark yellow layer at the top= no indole production= tryptophan not broken down/ hydrolyzed

what test is this?
what media is this?
was there something added?
interpret the results/ what’s positive and negative
indole production test
SIM agar deep tube
Yes- kovac’s reagent (10 drops)
leftmost= after incubation with no kovac’s reagent; middle= negative (no indole production bc no hydrolysis of tryptophan and so no tryptophanase); right= positive result (pink ring= indole production due to the presence of tryptophanase (broke down tryptophan)
what do the Methyl-Red and Voges Proskauer Test do?
they help to differentiate E.coli and K.aerogenes *by examining the organic acid end-products since both microorganisms ferment glucose to organic acids, but the acidity of the acids these microorganisms convert glucose to differs aka mixed-acid fermentation (E.coli is more acidic elow 4.4, while K. aerogenes is more basic (6.2 and above)
Methyl Red Test
what is it used for? (general)
what does it test for?
explain the breakdown of the thing this test tests for
what type of media is used?
do you need to add a reagent/ if so which one and how before interpreting results?
what do you look at to interpret the results?
positive looks like?/what does this mean?
negative result looks like?/ what does this mean?
to help differentiate members of the genus Enterobacteriaceae
determine the ability ferment glucose to make highly acidic end products (E.coli)
1) Glucose + H2O —> (lactic acid, acetic acid or formic acid +Methyl red —→ Co2 +H2 pH 4 (red color)= E.coli
MR/VP broth (has peptone, glucose, and phosphate buffer)
Yes- 1) transfer ½ of the MR-VP culture into an empty test tube with a pasteur pipet (for vogues-proskauer test and 2) add 5 drops of pH indicator methyl red indicator to the aliquot and examine the color (broth is originally orange)
positive results: MR-VP broth looks deep red (pH is below 4.4), glucose was fermented and made highly acidic end-products, most likely E.coli
negative results: 1) yellow (pH > 6.2) indicative of non-acidic end products (K. aerogenes most-likely) *if orange= further incubation required


what test is this
explain what was added to yield results
explain the pictures (+ or -) results and what each mean)
Methyl- Red test
pH Methyl red indicator
middle + right = negative (orange middle), right= yellow (non-acidic end products; not E.coli pH is > 6.2; left = red (pH 4.4) acidic end-products (all do have the fermentation of glucose)- E.coli probably!
Vogues Proskauer Test
what is it used for? (generally)
what does it test for?
explain the breakdown of the thing this test tests for
what type of media is used?
do you need to add a reagent/ if so which one and how before interpreting results?
what do you look at to interpret the results
positive looks like?/what does this mean?
negative result looks like?/ what does this mean?
to help differentiate members of the genus Enterobacteriaceae, finishes up methyl red test!
tests to see if an organism can produce acetoin from the degradation of glucose during 2,3,butanediol fermentation. determines if an organism can produce non-acidic or neutral end products such as acetylmethylcarbinol, from the organic acids that result from glucose metabolism in organisms like K. aerogenes
Glucose + H2O. —> (acetic acid)—> (2,3, butanediol acetylmethylcarbinol +methyl red)—→ Co2 +H2 pH 6 (yellow color)= K.aerogenes #2= Voges - Proskauer test!
MR/VP broth (has peptone, glucose, and phosphate buffer)
Yes! Barritt’s reagent (turns pink with diacetyl) add 15 drops and shake every 3-4 min for 15-30 min and record colors
look at the top of the tube
positive results: (tube will have a deep-rose colored product at the top), indicative that Barritt’s reagent reacts with the acetylmethylcarbinol end-product, and acetoin was produced (KOH converts acetoin into diacetyl), so if rose colored K. aerogenes the microorganism because it converts acids into acetoin and barritt’s reagent reacts with it
negative results: no rose color at top= not K. aerogenes and no acetoin

what test is this?
what type of media is this?
explain what was added to yield results
explain the pictures (+ or -) results and what each mean)

Voges- Proskauer test
MR-VP broth
Barritt’s reagent
left= negative (no acetoin production as the acetoin wasn’t broken down into diacetyl, which reacts with barritt’s reagent to make a pink color)
right= positive = rose colored ring= acetoin broken down into diacetyl which turned pink when barritt’s reagent was added
Citrate Utilization Test
what is it used for? (generally)
what does it test for?
explain the breakdown of the thing this test tests for
what type of media is used?
indicator? + explain, do you need to add it?
what do you look at to interpret the results
positive looks like?/what does this mean?
negative result looks like?/ what does this mean?
tests for the differentiation among enteric organisms based on their ability to use/ ferment citrate as a sole carbon source
tests to see if citrase is present/ organisms ability to use citrase (used when organisms can’t breaj down glucose or lactose)
citrate transport (via citrate permease—> sodium citrate into the cell (via citrase—> oxalacetic acid +acetic acid —> pyruvic acid, CO2, Na2Co3 (alkaline pH)
Simmons citrate agar slant (alkaline products if citrate present)
acid-based indicator dye: Bromothymol blue; turns from green (neutral pH 6.9) to blue when pH is above 7.6 and yellow when pH is below 6.0!
look at the color of the slant (performed via stab and drag) and growth
positive result: growth + blue color (citrate was used); CO2 end-product combines with sodium and H2O (in the simmons citrate agar slant medium) to form sodium carbonate (alkaline)
negative result: green color+ no growth change (negative citrate culture) no citrate utilization

what test is this?
what type of media is this?
explain what was added to yield results
explain the pictures (+ or -) results and what each mean)
citrate utilization test
simmons citrate agar slant
nothing was added but bromothymol blue is in the medium along with H2O and sodium, so when CO2 is produced as a result of citrate being broken down, it increases the alkalinity of the pH to above 7.6, making the mediu change from a green to blue
left= positive result (citrase used, citrate is main carbon source), right= negative result (no citrate utilization, no growth, and green)
which tests from the IMViC tests are qualitative assays?
Indole production
Citrate utilization
Indole and citrate are considered more purely qualitative because they give a direct yes/no result based on the presence of a single product or growth on a substrate, whereas MR and VP require interpretation of metabolic end products through indicator reactions.*
start of exercise 17
Hydrogen Sulfide Test
what does it test for?
explain the breakdown of the thing this test tests for
what type of media is used?
how is it performed?
indicator? + explain, do you need to add it?
what do you look at to interpret the results
positive looks like?/what does this mean?
negative result looks like?/ what does this mean?
tests for the ability to produce H2S (gas production) from sulfur-containing amino acids or inorganic compounds + motility
2 pathways: *DO I HAVE TO GO INTO THIS?
SIM agar
stab incoculation
NO! BUT the SIM agar has ferrous sulfate (FeSO4) which is an H2S indicator enhances anaerobic respiration * combines with H2S gas to form a black precipitate, ferrous sulfide
SIM agar (contains peptone, sodium thiosulfate (which can be reduced to sulfite and hydrogen sulfide gas + when combined with ), and FeSO4 which is an H2S indicator enhances anaerobic respiration * combines with H2S gas to form a black precipitate, ferrous sulfide
positive results: insoluble black ferrous sulfide precipitate is seen along tee line of the stab inoculation is (black produced as FeSO4 combines with gas) indicating H2S production , sulfur reduction
negative result: no black precipitate = no sulfur reduction
what test can detect motility and how?
H2S test
lower agar concentration in SIM medium allows for limited movement of motile bacteria from the area of the stab
motility is defined as diffuse growth from bacterial stab libe
SIM agar tests for what 3 things? and how?
Indole (indole production test)- 16
hydrogen sulfide (H2S test)- 17
Motility

what test is this?
what type of media is this?
explain what was added to yield results
explain the pictures (+ or -) results and what each mean)
lowkey a cominatin, but technically Indole production and H2S production Test
SIM agar deep tube
10 drops of kovacs reagent only (explains the red color because tryptophan was broken down)
Ex. 16 Indole | + | - | - | - | + |
Motility | + | - | + | + | + |
Ex. 17 Hydrogen sulfide | - | - | + | - | + |
Start of exercise 18
urease
a hydrolytic enzyme that attacks the nitrogen and carbon bond in amide compound like urea and forms the ALKALINE end product ammonia (NH3)
Urease test
what is the purpose of this test?
what does it test for?
what is it used to identify?
what type of media is used?
how is it performed?
indicator? and explain colors
what do you look at to interpret the results
positive looks like?/what does this mean?
negative result looks like?/ what does this mean?
determines the ability of microorganisms to degrade urea via urease
tests for the presence of urease, an enzyme that catalyses the hydrolysis of urea into CO2 + ammonia NH3
Proteus vulgaris *rapidly produces urease
Urea broth (originally orange)
loop inoculation
pH indicator phenol red (pink when pH > 8.4
positive result: orange —> dark pink color when pH is > 8.4, as a result of more ammonia being produced from the degradation of urease, and so the pH increases)
negative result: yellow= no urease activity

what test is this?
what type of media is this?
explain what was added to yield results
explain the pictures (+ or -) results and what each mean)
urease test
urea broth
nothing was added
left= negative result, pH is < 6.8 as a result of no urease activity (no alkaline products being produced); middle= nothing; right= dark pink= positive result, pH > 8.4, because ammonia (by byproduct of the degradation of urea ) turns phenol red pink
start of exercise 19
Litmus Milk Reactions
what’s the purpose
what does this test? for
what’s the medium?
indicator
results + interpretations
differentiates microorganisms ability to change litmus milk
tests for lactose fermentation, gas production, litmus reduction, curd formation, proteolysis, and alkaline reduction
litmus milk broth tube
litmus (naturally purple when pH is neutral)
results:
lactose fermentation: lactose (via galactosidase—> glucose +galactose —> lactic acid (litmus acts as a pH indicator and will turn pink when pH is about 4, lactic acid present and so medium is acidified galactosidase present
gas production: separations of curd or development of fissured within the curd if lactose if fermented end products are usually CO2 + H2
litmus reduction : litmus is an e- acceptor, in a reduced state, it’s white; oxidized= purple (produces lactic acid, butyric acid, CO2 + H2O)
curd (clot) formation: 2 types
acid curd: acid precipitation of casein milk protein + calcium caseinate form an insoluble clot. can’t move if tube is inverted*
rennet curd: formed from action of rennin enzyme (breaks down casein to paracasein + calcium —> insoluble rennet clot semi-solid and can move when it’s tube is tilted
proteolysis (peptonization): hydrolysis of milk proteins into amino acids —> high [ammonia]—> alkaline pH. Litmus milk turns deep purple in upper portion of the tube middle = brown/ translucent protein hydrolyzed into amino acids
alkaline reaction: unchanged or deep purple. partial degredation of casein into shorter polypeptides

what test is this
explain the results of each and why
litmus milk
left= proteolysis (translucent middle area= casein protein hydrolyzed into amino acids, deep purple on top= elevated pH due to deamination of milk proteins)
middle= acid clot (solid, pink acid on top) and reduced white acid on the bottom
right= semi-solid curd formation blue top= alkaline conditions (no lactose fermentation?)

what test is this
explain the results of each and why
litmus
left is alkaline conditions and reduced litmus at bottom
right= acid production (pink) and no acid clot formation or proteolysis
start of exercise 20
nitrate reduction test
what does this test? for
what’s the medium?- what’s special about it?
reagent?
results + interpretations
determine a microorganisms ability to reduce nitrates (NO3-) to nitrites (NO2-) vis nitrate reductase , trying to see if anaerobic respiration is taking place (nitrate= terminal electron acceptor
nitrate broth medium (0.1% KNO3 (potassium nitrate)
no reagent present at first!! bubble at the end of incubation in durham tube= complete reduction of nitrate to nitrogen! BUT if no gas in the durham tube, you have to add two reagents Solution A (sulfanilic acid) followed by solution b (alphanapthylamine)
once reagents are added:
if nitrate reduction to nitrites has occurred= cherry red
if there’s no nitrite (nitrous acid), medium won’t be red and will remain clear, then….
no red color= means that there’s an absence of nitrite and nitrate reagents won’t be converted to a red dye and medium will remain clear (because no nitrates were reduced by the organism, OR they were rapidly reduced beyond nitrites to ammonia or nitrogen via nitrate reductase, SO you then have to test for reduction to ammonia or nitrogen by adding zinc (catalyzes spontaneous reduction of nitrate to form nitrite and nitrous acid will accumulate causing nitrate reagents —> red (red= negative result)
if red when zinc is added = negative for nitrate reduction and nitrates are still present in the medium;
no color change + no gas in durham tube, then the test is positive for nitrate reduction and must be ammonia or nitrogen



what test and 2. explain results
nitrate reduction test
At left is an uninoculated control.
Second from left is a tube with nitrate reagents added, indicating the presence of nitrite.
The third tube from the left shows no reaction with the nitrate reagents indicating ammonia production
the fourth tube from the left shows a positive reaction upon the addition of zinc after the nitrate reagents had yielded a negative result, indicating that no nitrate has been reduced
start of exercise 21
catalase test
purpose
principle
medium
explain how to perform it
positive results
principle: helps distinguish catalase positive staph and microc. from the catalase neg streptococ.
tests for the presence of catalase (degrades H2O2 , hydrogen peroxide, into O2); seeing if hydrogen peroxide can be broken down gram + rods = bacillus = positive for catalase and clostridium is negative for this test (aerobes = hydrogen peroxide (via catalase—→ water + free O2; aerobes that lack catalase can use superoxide dismutase (degrades toxic superoxides to hydrogen peroxide)
tryptic soy agar plate, place a drop of H2O2 substrate on.a slide and mix it with a loopful of culture
positive results: bubbles (free O2 gas produced, so hydrogen peroxide broken down) ; negative result: no bubbles (no catalase) so you can have superoxide dismutase

what test and 2. interpret results
catalase test
positive results(right): bubbles (free O2 gas produced, so hydrogen peroxide broken down) ; negative result (left): no bubbles (no catalase) so you can have superoxide dismutase
exercise 22
oxidase test
what does it do?
why do we use this test
medium
how do you perform it
positive results + interpretation
negative results + interpretation
identify bacteria containing respiratory enzyme cytochrome oxidase (Enterobacteriacae = negative vs. Pseudomonadadceae= oxidase positive)
aerobic activity are associated with cytochrome c oxidase
tryptic soy agar plate
reagent = p-aminodimethylaniline oxalate (light pink naturally), turns black if oxidase + free oxygen present ; add a few drops of p-aminodimethylaninline to a t soy plate to see if the organism turns pink, maroon, and black colored colonies, no color change or light pink - negative result
(+) = color change in 10-30 seconds; negative test (-) = no color change, or light pink color.